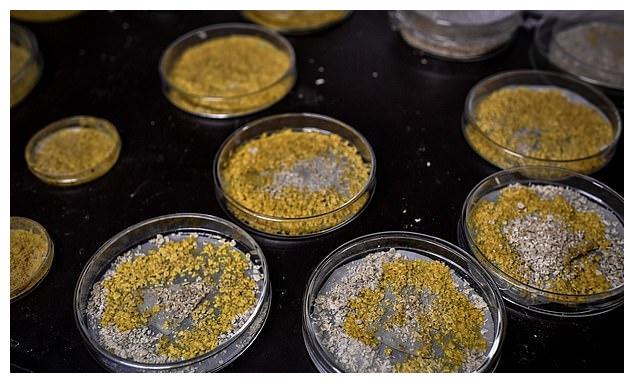

精选的变形怪体: 变形怪体来了!有720种性别切断可迅速再生

小镇的天空中突然坠落了一个天外来客,它是圆球形的球铁陨石状物体。然而居民们发现这个怪异的东西,居然像地球上的蛋壳一样,自动崩裂开来。里面出现了一团会动的果冻般粘稠的物体,村民试图用棍子去触碰它,结果这团东西迅速地粘在了村民手臂上,然后包裹在手臂上的果冻越变越大,吃人的变形怪体让小镇居民惊恐万分。
这样的情节听起来是不是有点惊悚,但是您不用害怕,这是1958年在美国上映的科幻片《变形怪体》中的情节。

现在现实版的变形怪体来了。巴黎一家动物园本周三出现了一种神秘的新生物,这种生物被称为“blob”,中文意思是难以名状的一团东西。它的名称也是上面提到的科幻电影的名字。
研究人员表示,这种黄色黏液状的东西是一种单细胞生物,它看起来像真菌,但行为实际上却像动物。这种生物有720个性别不分雄雌,实际上生物学家表示,这不是真正的性别,只是交配类型,它们能否交配取决于它的交配类型,这是由特定的基因决定的。

现在让我们来见识一下这种不同寻常的生物,它将于本周六出现在巴黎动物园的玻璃器皿里向公众展出,该展览也是首次向公众展示blob的罕见能力。
它们呈亮黄色,没有腿或翅膀却可以移动,每小时能够爬行4厘米。虽然它没有大脑,却能聪明地解决问题,如果你把它切成两半,它在两分钟内就能自我愈合。它还可以把自己分裂成不同的生物体,然后再融合在一起。它没有嘴,没有胃,没有眼睛,但却能够发现和消化食物。

巴黎自然历史博物馆馆长布鲁诺?大卫表示,blob是一个活生生的生物,是属于大自然的神秘物种之一。它们没有大脑,却能够相互学习,如果你把两团blob放在一起,一个团块可以把它获得的信息传递给另外一个团块。据动物园发布的一段视频显示,科学家最初在培养皿中培育这种微生物,喂它最喜欢的食物燕麦粥。一旦它长到一定的尺寸,生物学家就会把它嫁接到树皮上,树皮是它的食物来源。

据信,这种单细胞生物已经存在了数百万年年,但它第一次引起公众注意是在1973年5月,当时德克萨斯州的一名妇女在自家后院发现了一个正在迅速膨胀的黄色斑点。由于它奇特的天外来客的外表,blob一度在媒体上引起轰动,甚至被《纽约时报》进行了报道。这个来自德克萨斯州的小团快很快就消失了,直到2016年发表的新研究在科学界引起了轰动,世界才重新注意到了这了团奇怪的黏液。

研究人员表示,这种生物有学习的能力,它曾被粗略地定义为某种黏液霉菌。在2016年的一项实验中,研究人员发现他们可以教会Blob通过一座布满盐的桥,而盐最初是被Blob排斥的物质。此外他们还发现,当他们把这种黏液霉菌与另一种没有被教过如何通过桥梁的粘液霉菌结合起来时,学习能力就转移到了新的生物体中。
这种黏液霉菌的正式名称是多头绒泡菌,它既不是植物,也不是动物,也不是真菌。当温度在19到25摄氏度之间,湿度达到80%到100%时,它们就会疯狂成长。多头绒泡菌还可以学会忽视有害物质,并且1年后仍然能记住自己的行为。
因此,科学家们说blob可能能够通过某种类型的融合来传输知识。最初研究的重点已经锁定在了两个样本结合后形成的“静脉”上。
这种像蘑菇一样的东西,它的行为非常令人惊讶。它有动物的行为,还能够学习。blob被认为具有解决问题的能力,比如找到走出迷宫的最短路径,预测环境的变化、小心地平衡它们对特定营养物质的摄取等等。根据动物园的新闻发布,它几乎不会死,唯一的敌人是光和干旱,但它可以在受到威胁的几年内冬眠。

科学家们并不确定blob是如何执行这些任务的,因为它没有一个神经系统来指挥身体如何行动。一些人认为它们可能利用电信号传输信息,或者它可以通过它所有的分支发送电波来进行通信。
最近的研究表明,一种未知的信号分子最有可能对这种生物的复杂行为负责。该研究发表在《英国皇家学会学报》上,法国国家科学研究中心的生物学家奥德丽·达苏图尔是该研究的合著者。

